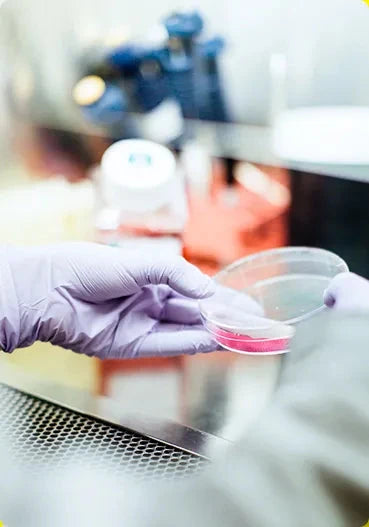

Ao acordar, você saberá que fez a escolha certa.
Uma combinação de 12 ingredientes
AMINOÁCIDOS
MINERAL
VITAMINAS
FÓSFOLIPIDIOS
A ciência em prol da saúde e bem-estar
Os excessos consumidos durante as comemorações podem comprometer o bom desempenho do organismo. Com os componentes nas dosagens certas, Reviv auxilia no metabolismo energético, na proteção dos danos causados pelos radicais livres e no funcionamento do sistema imune.
Para quem adora viver, Reviv

Churrasqueiros de plantão

Apreciadores de vinho

Fãs de happy hour
FAQ
Quando devo consumir Reviv?
Sugerimos que você tome as 3 cápsulas do pack juntas, com quantidade suficiente de água e preferencialmente 30 min antes de sair para o happy hour, churrasco, ou outros eventos.
A fórmula possui algum tipo de contraindicação?
O consumo não é indicado para grávidas, lactantes, menores de 19 anos e alérgicos à derivados de soja.
Diabéticos podem consumir o produto?
Sim. A fórmula de Reviv não contém açúcar.
Veganos podem consumir o produto?
Não, pois as cápsulas são compostas de gelatina, não indicadas para veganos.
Hipertensos podem consumir o produto?
Sim. Em casos de dúvida, consulte seu médico.
Posso tomar um dia seguido do outro?
Sim. A fórmula de Reviv contém as quantidades diárias indicadas.








